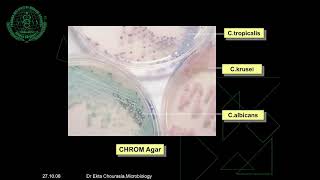

An Introduction to the MRC Centre for Medical Mycology
Professor Gordon Brown, Director of the MRC Centre for Medical Mycology at the University of Aberdeen, outlines the vision for the new Centre in tackling the ...
School of Medicine, Medical Sciences and Nutrition
Medical Mycology || Medically Important Fungi
Medical Mycology || Medically Important Fungi.
MedicoFem
Introduction to Clinical Mycology: Part 2 [Hot Topic]
Our speaker for this program is Dr. Glenn Roberts, a Professor of Laboratory Medicine and Pathology, and Microbiology as well as a consultant in the Division of ...
Mayo Clinic Laboratories
Mycology Microbiology|What is Mycology|Fungi|Fungi Characteristics|Saprophytes|Fungi Mycology
mycology microbiology|what is mycology|fungi|fungi characteristics|saprophytes| fungi mycology.
Last Night Study
Introduction to medical mycology – Prof Yee-Chun Chen
Professor Yee-Chun Chen is professor of medicine at the National Taiwan University Hospital and College of Medicine in Taipei, Taiwan, an investigator of the ...
Asia Fungal Working Group
Introduction to Mycology - مقدمة عن علم الفطريات
Pictures used are courtesy of Samuel Freire da Silva, M.D.(www.atlasdermatologico.com.br) Contact information: Facebook: ...
Dr. Mohamed Sherif Lectures
1. Introduction to medical mycology
Department of MLT, SMAS, Galgotias University.
BSc MLT online classes Vamsi
Medical mycology (theoretical ) Lecture 1
introductions of medical Fungi.
عبدالقادر كريم رميض
Medical mycology
It's a about how to study mycology.
Prashant Kore
FUNGI IN 15 Minutes | NEET PG | DR. HIMANSHU GUPTA
hey friends, I have created few videos that will help you to revise effectively after you have completed the topic. You can also use these videos before reading ...
Himanshu Gupta MAMC
Medical Mycology Revision "Part 1"
"Part 1" Medical Mycology Revision Find more about microbiology in our page "MicroRamziology" https://www.facebook.com/MicroRamziology Dr. Ahmed ...
Ahmed Ramzy
Introduction to medical mycology in hindi
This video contains the general introduction of medical mycology. Definition classification Diseases.
Kamal Dhariyal
Microbiology lecture|Introduction to Mycology|Mycology Microbiology|what is fungi|fungi
Hello friends, in this video you will learn about basic concepts of mycology . what is fungus, different morphology of fungus exist, hyphae, Yeast. Morphological ...
Basics of Microbiology by Dr. kiran
Career in Mycology – What makes a good medical mycologist?
Think working in mycology is all about data-crunching and scientific know-how? Our mycology experts beg to differ; to them, a good attitude is all that matters.
Asia Fungal Working Group
4.4. Yeasts and Dermatophytes-II - Medical Mycology
View the entire playlist here: https://www.youtube.com/playlist?list=PLwlvPe1bGTl-_8vBXsdCYForx8rWVAUZC This series of videos contains complete ...
Dr. Prodigious
Introduction to medical Mycology
This is an educational video. Introduction to medical mycology. It includes general properties of Fungus, its classification and different mycoses.
Kunjan kikani
فطريات نظري lec 1 / Introduction to Medical Mycology
Ali Al_Iraqi
4.5. Filamentous Fungi-I - Medical Mycology
View the entire playlist here: https://www.youtube.com/playlist?list=PLwlvPe1bGTl-_8vBXsdCYForx8rWVAUZC This series of videos contains complete ...
Dr. Prodigious
Interdisciplinary PhD training within the MRC Centre for Medical Mycology
Professor Al Brown describes a bespoke four-year MRes-PhD programme available within the MRC Centre for Medical Mycology at the University of Aberdeen.
School of Medicine, Medical Sciences and Nutrition
Medical Mycology
Dr. Sachin Deorukhar Prof. Microbiology Dept.RMC.Loni.
Pravara Institute Of Medical Sciences
Medical mycology LAB1 and2
Fungus isolation in general.
عبدالقادر كريم رميض
MSc Medical Mycology at The University of Manchester
Discover more about MSc Medical Mycology at The University of Manchester.
The University of Manchester
MYCOSIS | Medical Mycology| Microbiology Lectures
MYCOSIS Definition, Causes, Symptoms, Diagnosis, Treatment, Prevention Lecture#07 Medical Mycology Microbiology Lectures.
Biochem and Microbe Lectures by SHAISTA JABEEN
4.7. Dimorphic Fungi-I - Medical Mycology
View the entire playlist here: https://www.youtube.com/playlist?list=PLwlvPe1bGTl-_8vBXsdCYForx8rWVAUZC This series of videos contains complete ...
Dr. Prodigious
INTRODUCTION TO MEDICAL MYCOLOGY
Jaafar H.
Medical Mycology Ninth lecture (Superficial Mycoses)
By Hashmatullah Yousufi.
Hashmatullah Yousufi
What is the Impact of Anti-fungal Drug Resistance in Medical Mycology? | Professor Neil A.R. Gow
Professor Neil A.R. Gow discusses the impact of anti-fungal drug resistance in medical mycology. Professor Gow is co-editor of the Oxford Textbook of Medical ...
Oxford Academic (Oxford University Press)
Medical mycology
Ali Al-Dulaimi
Career in Medical Mycology – What attracted you to fungi?
In this video, AFWG board members discuss the attraction of working with fungi, and what they think about their career choice. Interested in getting involved in ...
Asia Fungal Working Group
Mycology part 2
MDSCONQUER II NEET MDS II AIIMS MDS II INBDE II MYCOLOGY.
SHREE’S MDS CONQUER
Paul Stamets: Mycology and Mushrooms as Medicines
Paul Stamets is a legendary mycologist, and in this tour de force keynote at Exponential Medicine (http://ExponentialMedicine.com) shares his work exploring ...
Exponential Medicine
Medical Mycology Revision
Medical Mycology Revision "2014" Find more about microbiology in our page "MicroRamziology" https://www.facebook.com/MicroRamziology Dr. Ahmed Ramzy ...
Ahmed Ramzy
Opportunities for clinical trainees within the MRC Centre for Medical Mycology
Professor Adilia Warris, Clinical Director of the MRC Centre for Medical Mycology outlines the opportunities for clinical trainees and medical students within the ...
School of Medicine, Medical Sciences and Nutrition
MRC Centre for Medical Mycology MRes-PhD Programme
This programme aims at providing an extensive foundation of knowledge and key skills for a subsequent PhD project, a choice of which will be offered to ...
School of Medicine, Medical Sciences and Nutrition
Anastasiya Kret - MRC Centre for Medical Mycology Summer Scholarship
Medical student, Anastasiya Kret, tells us about her experiences of an eight week summer scholarship funded by the MRC Centre for Medical Mycology where ...
School of Medicine, Medical Sciences and Nutrition
علم الاحياء الدقيقة-للتمريض فقط-المحاضرة العاشرة-الجزء الاول-Medical Mycology A-أ.ناهض عبد اللطيف
علم الاحياء الدقيقة-للتمريض فقط-المحاضرة العاشرة-الجزء الاول-Medical Mycology A-أ.ناهض عبد اللطيف.
أ.ناهض عزات عبد اللطيف
Microbiology Trial Lecture | Medical Mycology | Get Free Trial of Moksh LMS Program | Moksh Academy
Moksh Coaching is a personalized Medical Education Learning Platform. We are Providing FREE Moksh Online Coaching. GET A FREE TRIAL OF MOKSH LMS ...
Moksh Academy
The research vision of the MRC Centre for Medical Mycology
Despite their huge impact, fungal infections remain understudied and under-diagnosed compared with other infectious diseases and there is a pressing need for ...
School of Medicine, Medical Sciences and Nutrition
4.6. Filamentous Fungi-II - Medical Mycology
View the entire playlist here: https://www.youtube.com/playlist?list=PLwlvPe1bGTl-_8vBXsdCYForx8rWVAUZC This series of videos contains complete ...
Dr. Prodigious
Introduction to Medical Mycology
علم الفطريات Introduction to Medical Mycology.
الطريق الى النجاح
CMM214 T13 05:05 ntroduction to medical mycology
Ken Wuttisasiwat
4.2. Introduction to Mycology-II - Medical Mycology
View the entire playlist here: https://www.youtube.com/playlist?list=PLwlvPe1bGTl-_8vBXsdCYForx8rWVAUZC This series of videos contains complete ...
Dr. Prodigious